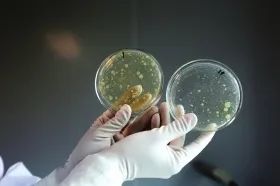

近日某网红雪糕因抽检不合格又双叒叕上热搜了↓↓↓

6月7日
国家市场监管总局公布
2019年国家食品安全监督抽检情况
抽检总体合格率为97.6%
但冷冻饮品等食品不合格率较高
微生物污染问题突出
今日,记者从江西省市场监管局了解到,日前该局已下发通知,部署开展"四查一打" (备案检查)剑指冷藏冷冻食品,切实保障人民群众生命安全和身体健康。
加强备案检查
根据国家市场监管总局公布的2019年国家食品安全监督抽检情况显示,从食品抽样品种看,冷冻饮品不合格率为6.1%,较上年下降,但仍处于较高水平,主要是微生物污染问题。 日前,江西省市场监管局下发通知要求,从事冷藏冷冻食品贮存业务的非食品生产经营者,应当自取得营业执照之日起30个工作日内向所在地县级市场监管部门备案,备案信息包括冷藏冷冻库名称、地址、贮存能力以及法定代表人或者负责人姓名、统一社会信用代码、联系方式等信息。
加强对委托方的检查
冷冻食品的安全隐患较为普遍,要保持冷冻食品的品质,对生产、运输、贮藏、销售等环节的条件要求都很高。
通知要求,从事冷藏冷冻食品贮存业务的非食品生产经营者(简称“委托方”)委托贮存、运输冷藏冷冻食品,应当选择具有合法资质的贮存、运输服务提供者(简称“受托方”),查验并留存贮存受托方的备案信息、运输受托方的统一社会信用代码等资质证明文件,建立受托方档案。
同时,委托方需审核受托方食品安全保障能力,监督受托方按照保证食品安全的要求贮存、运输冷藏冷冻食品。建立并落实冷藏冷冻食品全程温度记录制度。
加强对受托方的检查
若运输、储藏等环节中达不到-18℃的恒温冷藏条件,或放置时间过长,冷冻食品就会出现变形、变软或粘连等情况。
就此,通知要求,受托方应当按照相关标准或标签标示要求贮存、运输冷藏冷冻食品,加强贮存、运输过程管理,确保冷藏冷冻食品贮存、运输条件持续符合食品安全的要求,并按照委托方要求定期测定并记录冷藏冷冻食品温度。 受托方应当留存委托方的食品生产经营许可证复印件、统一社会信用代码等合法资质证明文件,如实记录委托方的名称、地址、联系方式以及委托贮存、运输的冷藏冷冻食品名称、数量、时间等内容;运输受托方还应当如实记录收货方的名称、地址、联系方式、运输时间等内容。 相关记录和凭证保存期限不得少于贮存、运输结束后2年。
加强对问题报告的检查
微生物污染、包装不完善、储存和运输过程中冷链环节不完善等,均会导致冷冻食品变质。 受托方在接受食品贮存、运输委托时,发现存在委托方无合法资质的;腐败变质或者感官性状异常的食品;病死、毒死、死因不明或者来源不明的畜、禽、兽、水产动物肉类及其制品;无标签的预包装食品;国家为防病等特殊需要明令禁止生产经营的动物肉类及其制品;其他不符合法律法规或者食品安全标准的食品等情形的,应当及时向所在地市场监管部门报告。
打击违法违规行为
通知明确,各级市场监管部门在加强冷藏冷冻食品安全监督检查中发现违法违规行为的,将依法严肃查处,同时追查冷藏冷冻食品来源和流向,涉及种植养殖、进出口、运输环节的,及时将违法违规情况通报农业农村、海关、交通运输等相关部门。 涉嫌犯罪的,按规定将线索移交公安机关。














